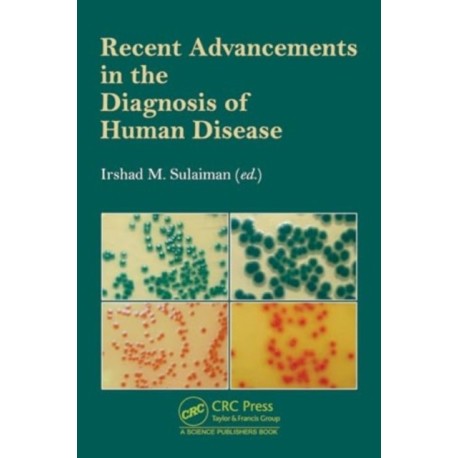
Recent Advancements in the Diagnosis of Human Disease

Kurv
Vare
varer
(tom)
Ingen varer
Fastlægges senere
Forsendelse
0,- kr
I alt
Recent Advancements in the Diagnosis of Human Disease
(Bog, Hardback, Engelsk)
Forlag:
Taylor & Francis Ltd
- Type: Bog
- Format: Hardback
-
Sprog:
Engelsk

- ISBN-13: 9781032572604
- Se flere detaljer ▼
Beskrivelse
This book entitled “Recent Advancements in the Diagnosis of Human Disease” will help the scientific community to better understand the transmission dynamics of some human diseases.
Læsernes anmeldelser (0)
Alle detaljer
| Forlag | Taylor & Francis Ltd |
| Type | Bog |
| Format | Hardback |
| Sprog | Engelsk |
| Udgivelsesdato | 14-06-2024 |
| Første udgivelsesår | 2024 |
| Illustrationer | 16 Tables, black and white; 10 Illustrations, color; 29 Illustrations, black and white |
| Fagredaktør | Irshad (U.S. Food and Drug Administration M. Sulaiman |
| Originalsprog | United Kingdom |
| Sideantal | 296 |
| Indbinding | Hardback |
| Forlag | Taylor & Francis Ltd |
| Sideoplysninger | 296 pages, 16 Tables, black and white; 10 Illustrations, color; 29 Illustrations, black and white |
| Mål | 242 x 160 x 22 |
| ISBN-13 / EAN-13 | 9781032572604 |

